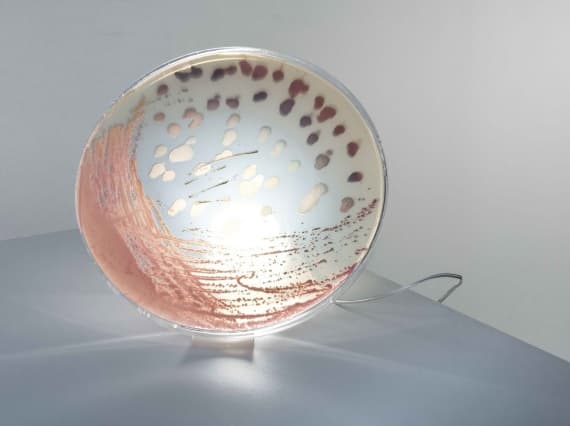
Ян Клингер превращает бактерии в свет

Ян Клингер превращает бактерии в свет
В рамках выставки Young Swedish Design в стокгольмском ArkDes дизайнер показал два варианта светодиодных ламп. Сам автор называет свои предметы линии Bacteria «современными ископаемыми». Одна из моделей представлена в виде круглого светильника, который можно использовать как настенный источник света. Вторая напоминает лабораторную колбу. Отличительная особенность всех объектов - диск с хаотичным природным рисунком. Клингер собирает бактерии, дрожжи и грибки и оставляет их на диске для выращивания в течение 24-48 часов. Таким образом создаются органические уникальные паттерны.